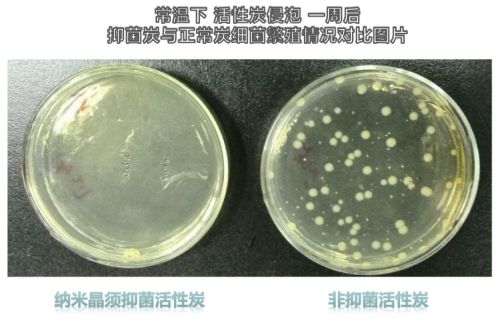

安吉尔航天级纳米晶须技术,只为一杯好水!
今年以来,全国多地发生数起饮水安全事故,敲响了饮用水安全的警钟,伴随着人们生活水平的提高,越来越多的人开始重视饮用水安全,净水器已成为很多家庭的标配家电。在选择净水器时,除了过滤效果,口感也是用户较为关注的问题。在这一方面,高端净水专家安吉尔将航天级纳米晶须技术应用于净水器中,大大提升了抑菌率,还原纯净口感。

目前,大多数净水器都会安装活性炭滤芯,用以去除水中的有机物、余氯、异味等,使水得到净化。但活性炭拥有巨大的空间结构,只要温度适宜,细菌滋生难以避免。有研究数据表明,细菌在25度环境下,活性炭内一个细菌存放4天将变成4000个以上。而采用纳米晶须与椰壳炭颗粒按特定的比例均匀混合应用到净水系统,可以有效阻止细菌在活性炭中的生长,抗菌率高达97%以上。
在这一过程中,纳米晶须和植物“光合作用”所需的“叶绿素”一样,都是作为一种催化剂存在,物理抑菌,无残留无毒害,更安全。经过其催化作用,会促使水中溶解氧产生高活性自由基,抑制细菌生长,而且抑菌效果持久,净化后的水3天内仍不滋生细菌。并且纳米晶须材料寿命有效期可长达20年,保证了其长效抑菌的效果。
这一研究成果的发现与应用离不开安吉尔与西南交通大学高分子材料研究的共同努力。2014年,安吉尔与西南交通大学高分子材料研究所达成战略合作,共建水质实验室,开展“复合催化抗菌抑菌,环境净化材料及其技术应用”的课题研究,共同研发抑菌型净水材料。同时这一课题也是国家高技术研究发展计划(863计划)的重要课题,其研究成果纳米晶须材料已被作为唯一抗菌材料样品入选“探月计划”,为太空水处理提供安全饮用水保障。
为了让更多人享受到这一研究成果,深耕净水行业33年的安吉尔将纳米晶须材料成功地应用到了安吉尔的净饮水设备中,只为用户能够享受到一杯好水。今年畅销的A7lite大水量净水器就采用了纳米晶须活性炭技术,长效抑菌保障加上纯净的口感体验,有效提升了饮水品质,也因此获得了用户的一致好评,取得试销五个月高端净水产品销量第一的好成绩。未来,安吉尔将继续不断钻研,坚持技术革新,让越来越多中国家庭享受到先进科技带来的健康安全水质。
网址:安吉尔航天级纳米晶须技术,只为一杯好水! https://www.jiaju82.com/news-view-id-721733.html
